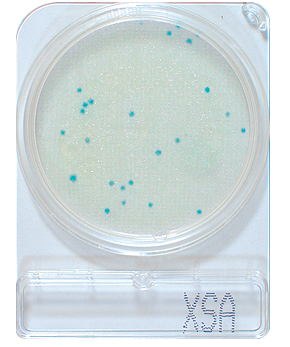
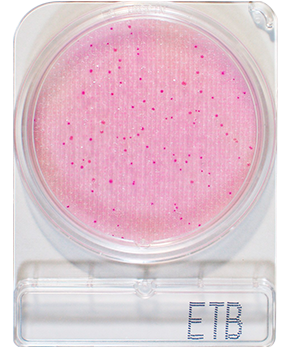

Productos
Sistemas Compact Dry
El método sencillo para la detección de microorganismos
Compact Dry es un procedimiento sencillo y seguro de determinar y cuantificar microorganismos en productos alimenticios, cosméticos y otras materias primas, incluidas las farmacéuticas.
Las placas cromógenas de Compact Dry listas para el uso son adecuadas tanto para los controles a realizar durante el proceso como para los del producto final. Con el Compact Dry Swab opcional usted podrá usar las placas Compact Dry también como placas de transferencia y de este modo realizar de forma sencilla una monitorización cuantitativa de la higiene incluso en superficies difíciles. Menos tiempo dedicado, más resultados.
Las placas Compact Dry son extremamente fáciles de manejar, basta con pipetear 1 ml de la muestra sobre la placa Compact Dry y esperar hasta que quede difundida de forma homogénea por toda la superficie de la placa. A continuación se incuba la placa según las prescripciones del prospecto. Gracias a los indicadores redox y a los sustratos cromógenos, las colonias bacterianas crecen en colores específicos, pudiendo así distinguirse e identificarse con suma facilidad. Para posteriores estudios, a continuación se pueden extraer fácilmente colonias específicas por separado.
Las placas Compact Dry se pueden almacenar sin frigorífico a temperatura ambiente hasta un periodo de 24 meses. De este modo, en caso de necesidad usted puede aplicar muestras directamente sobre el terreno o realizar monitorizaciones de higiene in situ con el Compact Dry Swab. La tapa con cierre giratorio permite transportar las muestras con seguridad. Las placas se incuban a continuación a la temperatura que se especifique para el caso entre 20° C y 42° C. Gracias a su estudiadísima forma se pueden apilar fácilmente y sin que resbalen: así se ahorra espacio y se mantiene la visibilidad dentro del incubador.
| Producto | Tiempo de incubación | Temperatura de incubación |
| Compact Dry TC para índice de germinación total | 48 horas | 35 ± 2° C ( 20 – 42° C ) |
| Compact Dry EC para E. coli y coliformes | 24 horas | 35 ± 2° C |
| Compact Dry CF para coliformes | 18 – 24 horas | 35 ± 2° C 40 – 42° C para coliformes fecales |
| Compact Dry YM para levaduras y mohos | 3 – 7 días | 25 – 30° C |
| Compact Dry SA para staphylococcus aureus | 48 horas | 35 – 37° C |
| Compact Dry VP para vibrio parahaemolyticus | 18 – 24 horas | 35 – 37° C |
Caractéristicas
- Empaque metálico (4 unidades desprendibles por paquete.)
- Fácil de almacenar (Temperatura ambiente)
- No requieren refrigeración
- De fácil transportación por su cierre hermético
- Amplia fecha de caducidad (12- 18 meses)
- Ahorran espacio
- No se requiere de áreas especializadas de laboratorio para su manejo
- Fácil de desechar